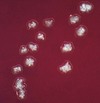

Actinomyces y Nocardia Flashcards
(33 cards)
Agente etiológico de Actinomicosis
Actinomyces Israeli
Características microbiológicas de Actinomyces israeli
Bacilo gram positivo, anaerobio, filamentoso, no formador de esporas, no movil
Actinomyces tiene una gran similitud microbiológica con cual microorganismo?
Nocardia
Principales diferencias microbiológicas entre Actinomyces y Nocardia
Nocardia es AFB, Actinomyces no lo es. Nocardia es catalasa positivo, Actinomyces es negativo
Método de cultivo para Actinomyces
Agar sangre
Apariencia característica de Actinomyces en cultivo de agar sangre
Apariencia de diente molar
Sitios de colonización de actinomyces israeli
- Espacios interdentales y entre las encias (gingivales)
- Nasofaringe
- Tracto gastrointestinal
- Tracto genitourinario
Principales condiciones clínicas que vuelven al huesped susceptible a infección por Actinomyces israeli
DM, HIV, malignidad y mala higiene bucal
Es la forma clínica más comun de actinomicosis
Actinomicosis cervicofacial
Mecanismo de infección de actinomyces israeli causante de actinomicosis cervicofacial
Erosión de la mucosa oral por trauma facial o intervención quirúrgica craneofacial o dental
Es la característica clínica principal de la actinomicosis cervicofacial

Formación de abscesos faciales
Los abscesos faciales de actinomicosis tienen la característica que …
Fistulizan al exterior
Complicaciones principales de la actinomicosis cervicofacial
Osteomielitis maxilar, mandibular, u OMA
Son otras presentaciones clínicas de actinomicosis
- Actinomicosis respiratoria (laringe-pulmón)
- Actinomicosis abdominal
- Actinomicosis genitourinaria (rara)
Sitio más común de afección gastrointestinal por actinomicosis abdominal
Apéndice y región ileocecal
Método diagnóstico de actinomicosis
Tinción y cultivo de exudado proveniente del absceso fistulado
Tratamiento de elección en actinomicosis
- Penicilina G
- Doxiciclina o Clindamicina en casos de alergia
Características microbiológicas de Nocardia
Bacilo gram positivo, Aerobio, filamentoso, no formador de esporas, no movil, AFB, catalasa +, ureasa +
Medios de cultivo para crecimiento de Nocardia
Agar sangre, Agar chocolate, Lowenstein-Jensen, Thayer-Martin modificado, Saboraoud
Mecanismo de contagio de Nocardiosis
A traves de piel erosionada o inhalación
Factor de virulencia de nocardia que impide la fusión del fagosoma-lisosoma dentro del macrófago
Dimecolato tehalosa o factor cord
Son las dos enzimas que utiliza nocardia como mecanismos de defensa en contra de la lesión oxidativa producida por neutrófilos y macrófagos
Superóxido dismutasa para los radicales superóxido
Catalasa para el peróxido de hidrógeno (H2O2)
Es la forma de presentación clínica más común de nocardia
Nocardiosis pulmonar
Histopatologicamente, la nocardiosis pulmonar se aprecia como
Granulomatosis y Necrosis caseosa
